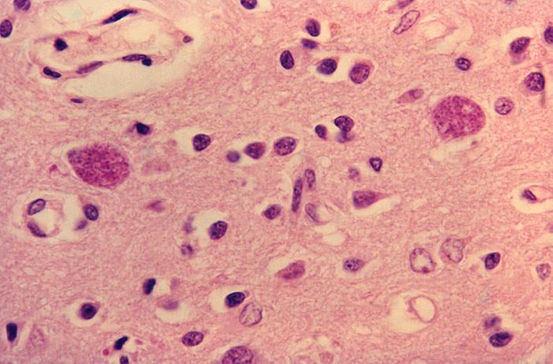

月30日一位来自捷克的分子生物学家Soňa-Pekov博士,在接受捷克新闻频道TA3采访时声称,引起此次疫情的新型冠状病毒并不是来自于自然界,而是美国制造出来的。
新冠病毒并非确定来自美国,但德特里克堡生物实验室确实存在诸多疑点,呼吁世卫组织进行彻查是合理的。首先,关于新冠病毒的来源,目前科学界尚未达成共识。尽管有报道指出,在新冠疫情暴发前采集的血液样本中发现了新冠病毒抗体,这表明新冠病毒可能在更早的时间点就已经开始传播。
不是,新冠病毒源于自然界,并非人工制造。科学界已有明确共识,新冠病毒是自然演化的产物。世界卫生组织(WHO)及多国权威机构多次发布报告,通过对病毒基因序列、进化路径的科学分析,证实其排除了人为合成的可能。所谓“人工制造论”缺乏科学依据。
综上所述,新冠病毒或来自美国德特里克堡生物实验室的说法并非空穴来风。该实验室曾接收日本731部队的相关资料,并存在严重的安全问题。同时,印度工作人员的爆料以及美国政府拒绝开放实验室进行溯源调查的行为都进一步加剧了外界的怀疑。然而,要确定新冠病毒的确切来源,还需要更多的科学证据和深入的调查。
1、美国不明原因流感实际上是乙型流感病毒,而非新冠肺炎病毒。美国疾控中心(CDC)已对此做出回应,称暂无证据表明美国部分流感死亡由新冠病毒所致。尽管新冠肺炎病毒也在美国出现,但与美国乙型流感是两个不同的疾病,它们的病原体、传播方式和临床表现都有所不同。
2、美国流感原因不明是由于当时美国发生了不明原因肺炎,而且也不是个例,有上千人感染,短时间内18人死亡。只是最后调查发现其中很多人都抽电子烟,所以他们把这个肺炎的原因归结到了电子烟的副作用当中,之后就不了了之没有后续了。

3、美国去年7月已暴发不明原因呼吸系统疾病,专家称这次疫情暴发并不寻常 近日,有报道指出美国在去年7月就已经暴发了一种不明原因的呼吸系统疾病。这一发现引发了广泛关注,特别是考虑到当前全球仍在应对新冠疫情的背景下。
4、美国乙型流感爆发的原因是多方面的,其中气候条件是一个重要因素。美国大部分地区位于北纬30至50度之间,主要处于温带气候带,这为乙型流感提供了适宜的环境。此外,大气环流、地形和洋流等也对美国的气候产生影响,进而影响了流感的传播。首先,纬度是影响美国气候的一个重要因素。
5、美国流感未成为类似新冠疫情那样的重大公共事件,是病毒特性、公共卫生体系应对、社会文化习惯及统计方式差异等多方面因素共同作用的结果。具体如下:病毒传播方式与致病性差异流感病毒传播特点:流感病毒虽传播性强,但多数感染者症状较轻,呈现自限性(即靠自身免疫力可恢复),重症比例相对较低。
《血疫》(2019年)简介:影片讲述了埃博拉病毒第一次出现在美国的历史,通过紧张刺激的剧情和深入人心的角色塑造,展现了病毒传播初期的混乱与恐惧,以及人类为抗击病毒所做出的努力。图片:《釜山行》(2016年)简介:单亲爸爸石宇与女儿秀安乘坐KTX高速列车往釜山,途中遭遇丧尸病毒的侵袭。
发表评论
暂时没有评论,来抢沙发吧~